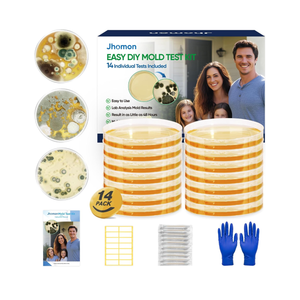
Mold Test Kit for Home, 14 Simple Mold Detectors with Detailed Mold Identification Guide, DIY Mold Testing Kit for Home Surfaces & Indoor Air Quality & HVAC & Car, Results in 48 Hours, 14PCS

Granite, Marble & Stone Repair Kit - Fix Chips & Defects in Minutes | Restore Tiles & Countertops with Ease | for Quartz Corian Marble or Stone | Flawless Results Every Time | Repair Up to 20 Chips
Condition: Appears New
Pickup Details
| Friday, Feb 6 | 09:00AM - 02:00PM (Appointment only) |
| Saturday, Feb 7 | 08:30AM - 02:00PM |
| Monday, Feb 9 | 11:00AM - 06:30PM (Appointment only) |
| Tuesday, Feb 10 | 12:00PM - 06:30PM |
Product Details
| SKU | OLARR6433099 |
| ASIN | B07N2GRRK1 |
Discover the details! Click here to explore this item category and more in our blog.